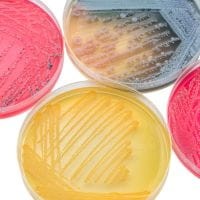
MRS Agar modified with Chalk gotowa pożywka na płytkach
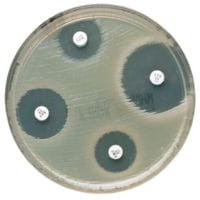
Mueller Hinton Agar gotowa pożywka na płytkach do oznaczania lekowrażliwości

Znaleziono produktów: 287
 MKTTn Enrichment Broth gotowa pożywka w probówkach 50x10ml
MKTTn Enrichment Broth gotowa pożywka w probówkach 50x10ml
Dodatki wybiórcze
Producent:
Oxoid
Cena:
158,74 zł
(netto:
129,06 zł
)
zawiera 23% VAT, bez kosztów dostawy
MRS Agar modified with Chalk gotowa pożywka na płytkach
MRS Agar modified with Chalk gotowa pożywka na płytkach
Podłoża gotowe na płytkach
Producent:
Oxoid
Cena:
174,79 zł
(netto:
142,11 zł
)
zawiera 23% VAT, bez kosztów dostawy
Mueller Hinton Agar gotowa pożywka na płytkach do oznaczania lekowrażliwości
Mueller Hinton Agar gotowa pożywka na płytkach do oznaczania lekowrażliwości
Podłoża gotowe na płytkach
Producent:
Oxoid
Cena:
19,81 zł
(netto:
18,34 zł
)
zawiera 8% VAT, bez kosztów dostawy
 Mueller Hinton Agar with Sheep Blood gotowa pożywka na płytkach do oznaczania lekooporności
Mueller Hinton Agar with Sheep Blood gotowa pożywka na płytkach do oznaczania lekooporności
Podłoża gotowe na płytkach
Producent:
Oxoid
Cena:
25,62 zł
(netto:
23,72 zł
)
zawiera 8% VAT, bez kosztów dostawy
 MYP Agar (Mannitol Egg Yolk Polymyxin Agar) gotowa pożywka do oznaczania Bacillus cereus
MYP Agar (Mannitol Egg Yolk Polymyxin Agar) gotowa pożywka do oznaczania Bacillus cereus
Podłoża gotowe na płytkach
Producent:
Oxoid
Cena:
44,80 zł
(netto:
36,42 zł
)
zawiera 23% VAT, bez kosztów dostawy
 Neisseria Selective Medium PLUS gotowa pożywka na płytkach do izolacji chorobotwórczych gatunków Neisseria
Neisseria Selective Medium PLUS gotowa pożywka na płytkach do izolacji chorobotwórczych gatunków Neisseria
Podłoża gotowe na płytkach
Producent:
Oxoid
Cena:
30,07 zł
(netto:
27,84 zł
)
zawiera 8% VAT, bez kosztów dostawy
 Nutrient Agar gotowa pożywka na płytkach Petriego do ogólnej hodowli mikroorganizmów
Nutrient Agar gotowa pożywka na płytkach Petriego do ogólnej hodowli mikroorganizmów
Podłoża gotowe na płytkach
Producent:
Oxoid
Cena:
26,64 zł
(netto:
21,66 zł
)
zawiera 23% VAT, bez kosztów dostawy
 Odczynnik indolowy RapID™ Spot
Odczynnik indolowy RapID™ Spot
Testy diagnostyczne i kontrole
Producent:
Oxoid
Cena:
165,13 zł
(netto:
152,90 zł
)
zawiera 8% VAT, bez kosztów dostawy
 Odczynnik RapID™ Nitrate A
Odczynnik RapID™ Nitrate A
Testy diagnostyczne i kontrole
Producent:
Oxoid
Cena:
153,15 zł
(netto:
141,81 zł
)
zawiera 8% VAT, bez kosztów dostawy
 Odczynnik RapID™ Nitrate B
Odczynnik RapID™ Nitrate B
Testy diagnostyczne i kontrole
Producent:
Oxoid
Cena:
157,18 zł
(netto:
145,54 zł
)
zawiera 8% VAT, bez kosztów dostawy
 Oxoid R2A Agar płytki gotowe do kontroli jakości wody, bakterie heterotroficzne
Oxoid R2A Agar płytki gotowe do kontroli jakości wody, bakterie heterotroficzne
Podłoża gotowe na płytkach
Producent:
Oxoid
Cena:
32,33 zł
(netto:
26,28 zł
)
zawiera 23% VAT, bez kosztów dostawy
 Oxoid™ Lab Lemco No. 2 Ekstrakt wołowy sypki 500g
Oxoid™ Lab Lemco No. 2 Ekstrakt wołowy sypki 500g
Podłoża sypkie
Producent:
Oxoid
Cena:
642,00 zł
(netto:
521,95 zł
)
zawiera 23.00% VAT, bez kosztów dostawy
darmowa i wygodna wysyłka
już od 800 zł netto
Najwyższa jakość
produktów potwierdzona certyfikatami
Zakupy 24h na dobę
wygodne i bezpieczne
bezpłatna konsultacja
z ekspertem online


